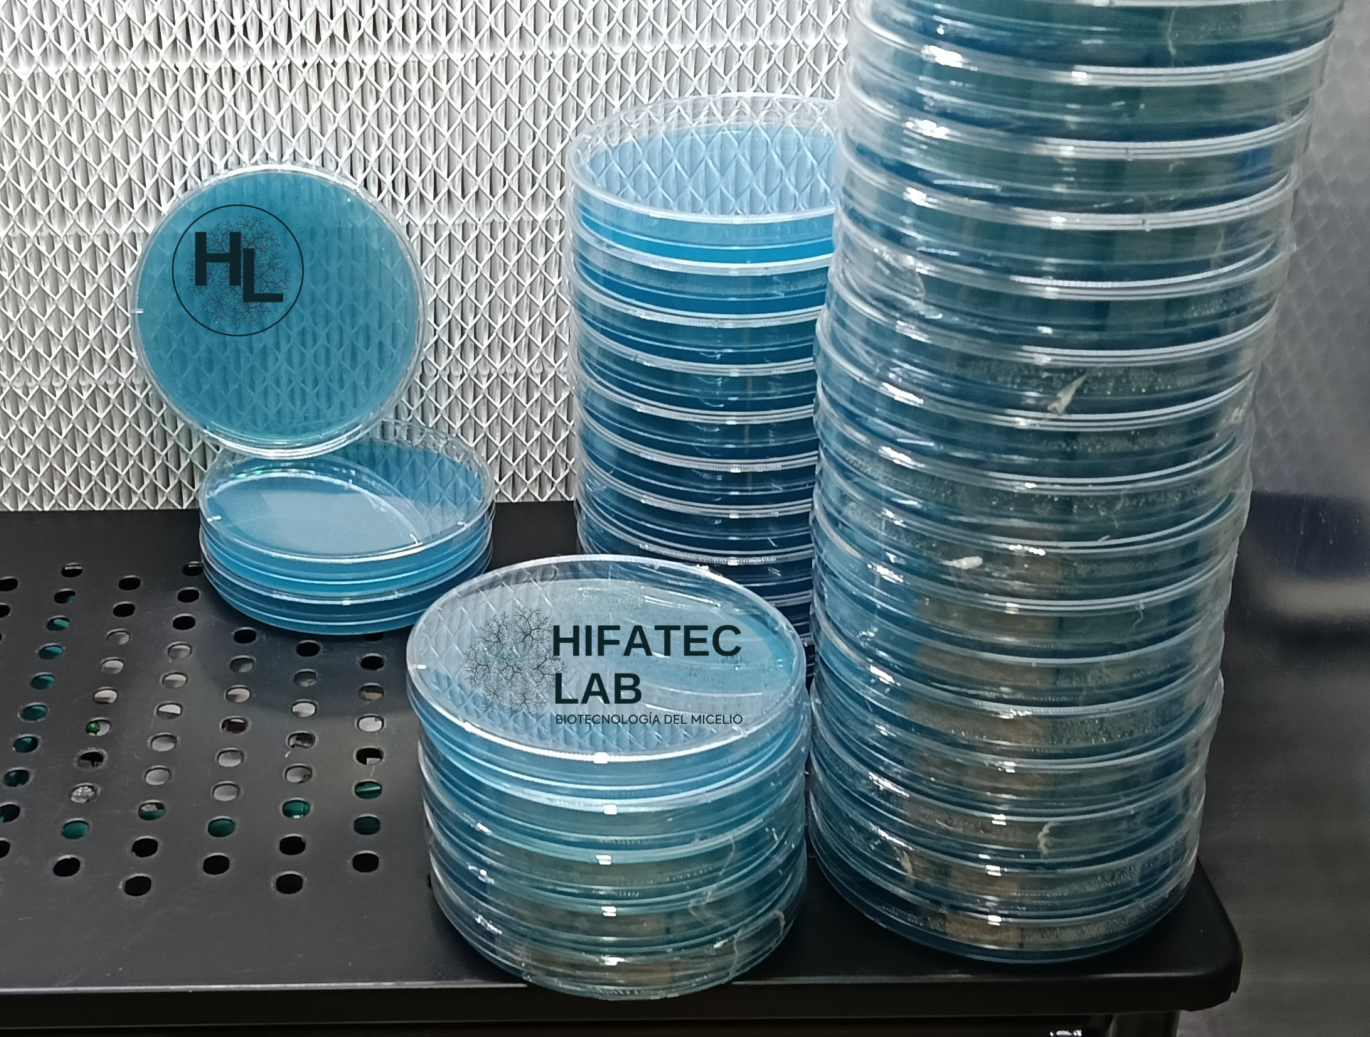

Optimiza tu flujo de trabajo con placas listas para el laboratorio.
Este paquete de 10 placas Petri preparadas con Extracto de Malta Agar (MEA) está diseñado para micólogos que buscan precisión y limpieza absoluta. Cada placa ha sido vertida siguiendo estrictos protocolos de esterilidad frente a campana de flujo laminar, garantizando un medio libre de contaminantes y listo para recibir tu genética.
El medio MEA es el estándar de oro para el cultivo de hongos, proporcionando una base nutricional rica que favorece el crecimiento de micelio vigoroso y facilita la identificación de sectores saludables para tus aislamientos.
Lo que recibes:
Esterilidad Garantizada: Vertidas en ambiente controlado con flujo laminar grado laboratorio.
Listas para usar: Sin necesidad de esterilización previa; solo desempaca e inocula en tu área de trabajo estéril.
Fórmula Nutritiva: Mezcla balanceada de extracto de malta y agar para un desarrollo micelial óptimo.
Versatilidad: Ideales para aislamientos desde esporas, transferencias de tejido (clonación) o limpieza de cepas.
Especificaciones técnicas:
Cantidad: 10 piezas por paquete.
Medio: MEA (Malt Extract Agar).
Presentación: Placas de 90mm selladas para mantener la integridad del medio.

Valoraciones
No hay valoraciones aún.